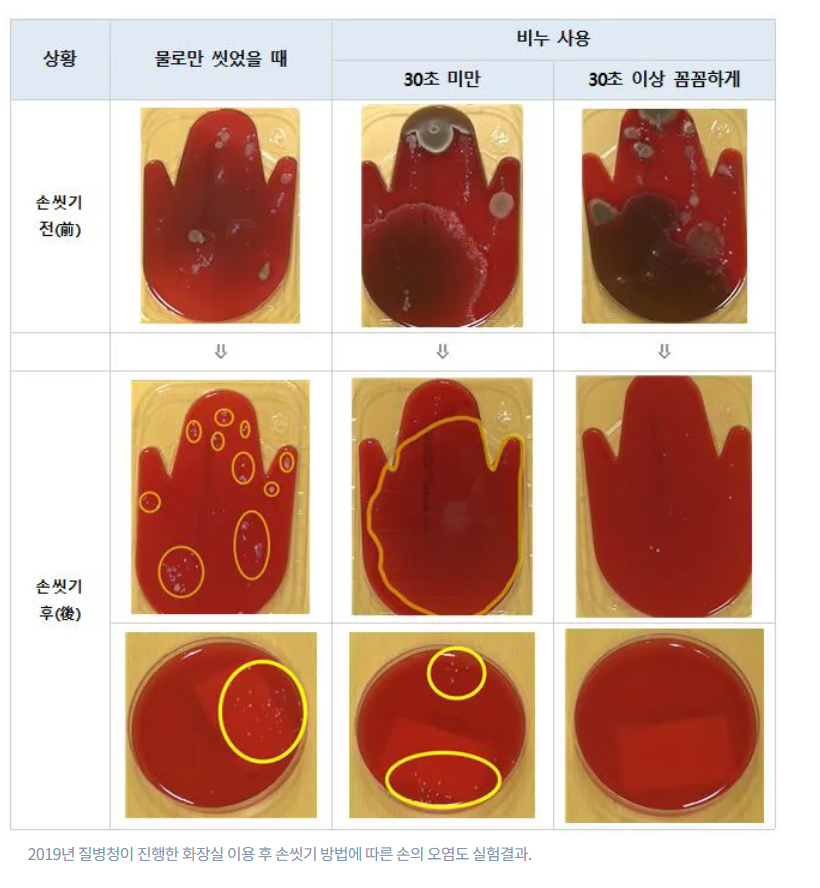

목차
질병관리청에서 21년 지역사회 감염병 예방 행태 실태조사를 공개하였습니다.
개인위생을 위해서 용변 후에 손씻는 것은 무척 중용한데요.

한국에서 용변후에 비누를 활용해서 손 씻는 비율은 30%에 불과하다고 합니다.

특히 손을 물로만 씻으면 세균 등이 잘 없어지지 않기 때문에
꼭 비누로 씻는 것이 중요한데요.

이 때에도 비누로 30초이상 꼭 손바닥, 손등, 손가락사이, 두손모아, 엄지손가락, 손등 밑까지 씻어주는게 중요합니다.
로만 씻은 실험자는 씻기 전 손이 가장 깨끗한 상태였지만 씻은 후에는 가장 많은 세균이 남아있었다.
비누를 사용했지만 30초 미만으로 문지른 실험자의 손에도 세균이 상당량 존재했다.
비누로 30초 이상 꼼꼼하게 씻은 실험자의 손은 씻기 전 가장 많이 오염된 상태였지만
씻은 후에는 세균이 가장 적었습니다.
이처럼 비누로 30초 이상 씻는 습관은 건강에 가장 중요한 습관입니다.

특히 코로나 19 이후로 개인 위생이 중요해졌고,
화장실의 경우 대장균, 살모넬라균, 황색포도상구균 등 인간에서 해로운 균들이 주로 서식하는 공간입니다.
그리고 대변 소변 후에 물을 내릴때의 배설물의 미세한 입자는 최대 공중 6M높이까지 날아간다고 합니다.
당시 실험에서 연구진은 변기 물에 염색약을 푼 뒤, 물을 내릴 때 얼마나 많은 양의 물방울이
주위로 튀는지를 확인했는데요.
그 결과, 물을 한번 내릴 때마다 최대 50방울의 변기 물이 변기 밖으로 날아가는 것으로 나타났다.
물방울의 최대 비(飛)거리는 6m에 달한다는 조사 결과도 있습니다.
그렇기 때문에 꼭 화장실에서 용변을 본 뒤에는 뚜껑을 닫고, 30초이상 비누로 손씻는 것이 중요합니다.
'Health' 카테고리의 다른 글
| 장염도 전염이 되나요? 장염에 대한 모든것 정리 (0) | 2022.11.17 |
|---|---|
| 목감기 인후염 증상 치료 방법 (1) | 2022.11.16 |
| 발건강 주의보 - 무좀 증상 치료 방법 알아보기 (0) | 2022.11.12 |
| 알러지 결막염 증상과 치료 정보 (1) | 2022.11.11 |
| 나와 이웃을 살릴 수 있는 심폐소생술(CPR) 5분만에 알아보기 (0) | 2022.11.09 |
